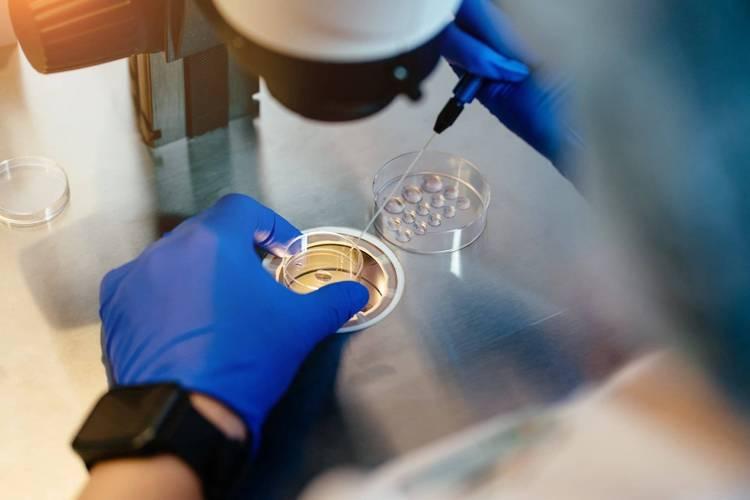

爲啥每次產檢正常,還會生出畸形寶寶?醫生說出原因:很無奈
文|菁媽
廣西桂林有一個媽媽懷孕的時候一直堅持去做產檢,產檢的時候每次都是正常,但是孩子出生後媽媽卻被嚇了一跳。原來這個孩子是有先天性畸形二度脣齶裂,而且還伴有牙槽裂,雙耳聽力不通過……
這其實是一種比較嚴重的畸形,所以媽媽非常憤怒,打算去相關部門起訴這個醫院。
類似這樣的案例還真不少,幾乎每一家醫院都有碰到過。

爲什麼每次產檢都正常,還會生出畸形的孩子呢?
最常見的排除畸形的檢查其實就是B超,比如說在12周左右做的NT檢查,比如說在20周左右做的大排畸,到了32周之後再一次的排畸,這些都是B超檢查。
我們拿到一張B超的檢查單會發現上面就是黑白地照片,能看到孩子模糊的樣子,但是並不是特別清楚。
所以這些檢查只能夠排除65%~70%的畸形,還有30%~35%的畸形是沒有辦法排查的。

原因有很多個
第1個:胎兒不太配合
比如說胎兒每一次都握拳,這時候你就沒有辦法看出孩子到底有沒有多指畸形,這類輕微的肢端畸形可能在B超的時候沒有辦法看出。
特別是有一些人本身就有遺傳性多指的,很可能孩子會有,這時候去照B超讓醫生幫看,有時候也不一定看得到,因爲孩子每次都握拳。
但這種畸形其實問題不大,出生之後給孩子動個小手術就能恢復了。

第2個:B超沒有辦法看到孩子皮膚的顏色
比如說有一種讓人看起來覺得非常可怕的先天性疾病叫獸皮痣,也就是孩子身上的皮膚像動物的皮一樣是黑色的,還有長了很多的毛髮。這種疾病是B超沒有辦法查出來的。
河南商丘就有一個孩子,在產檢的時候也是一路綠燈,孩子出生的時候卻是滿身的獸皮痣。看到這個孩子的樣子真的會被嚇一大跳,全身估計有一小半的皮膚都是長得黑黑的,像黑豬皮一樣,而且看起來皮膚比較粗糙。
醫生說這種病情確實可以治療,但是需要300多萬,這對於家庭來說是一個極大的負擔。

第3個:聽力、視力之類也沒有辦法看到
比如說孩子聽力有沒有問題,孩子視力有沒有問題,這個是沒有辦法通過B超判斷的,即使在B超中能看到孩子睜眼睛,但是孩子是不是青光眼?孩子的眼睛看不看得到你?B超中也沒有辦法看到。
聽力更加是沒有辦法看到,因爲我們現在聽力都是利用檢測儀器來檢測,在很早以前是用音叉來檢測,看看孩子有沒有聽到。所以在媽媽的肚子裏面是沒有辦法檢查聽力視力的,我們在孩子出生之後就要進行聽力的篩查,就是因爲要看看孩子是先天性的還是後天的。

第4個:一些隱藏的病也是沒有辦法看到的
孩子出生之後必須要在醫院住院幾天,然後醫生會問:孩子拉大便沒有?拉小便沒有?因爲這個是非常重要的一個指標。
如果孩子出生後第一天沒有拉大便,可能是先天性的腸道閉鎖,又或者是有一些女孩子叫石女的,也就是陰道閉鎖的,這個是B超沒有辦法查出來的,只有在孩子出生之後,通過觀察才能夠知道。
第5個:一些基因疾病也是沒有辦法看到的
比如說漸凍症,或者是企鵝病等等,這些是屬於基因病,如果家族是有這樣的遺傳史的話,建議就不要自然受孕了,可以考慮做第三代試管,這樣就可以避開這些有問題的胚胎,能夠懷上健康的孩子。
所以爲什麼產檢正常還會生出有問題的孩子,大部分的情況是跟醫生沒有關係的,確實也是現在的醫療條件受限。
並不是說產檢就沒有用了,產檢還是能篩查大部分的畸形,所以產檢該做還是做,但是孩子出生之後各種篩查也要跟上。
(圖片均來源於網絡,侵權立刪)

















